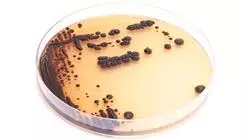
##IMAGE##

Universitäre Qualifikation
Die größte Fakultät für Medizin der Welt"
Präsentation
Dank dieses 100%igen Online-Kurses werden Sie die wirksamsten Strategien zur Kontrolle der Ausbreitung mikrobieller Resistenzen im Lebensmittelbereich entwickeln und umsetzen“

Nach Angaben der Weltgesundheitsorganisation sind Infektionen mit antibiotikaresistenten Bakterien weltweit mit etwa 700.000 Todesfällen pro Jahr verbunden. Die Organisation geht davon aus, dass diese Zahl in den kommenden Jahren steigen wird, wenn keine wirksamen Maßnahmen ergriffen werden. Angesichts dieser Realität müssen die Ärzte eine aktive Rolle in diesem Bereich spielen, da sie für die Diagnose und Behandlung dieser durch multiresistente Bakterien verursachten Infektionskrankheiten verantwortlich sind. Es ist daher von entscheidender Bedeutung, dass diese Spezialisten bei den innovativsten Techniken zur Verringerung der Ansteckungsgefahr an vorderster Front stehen.
In diesem Zusammenhang präsentiert TECH einen bahnbrechenden und hochmodernen Universitätskurs in Multiresistente Bakterien in der Nahrungskette. Der Studiengang wird sich auf die verschiedenen antimikrobiellen Resistenzen in Lebensmitteln (einschließlich ESBL, MRSA und Colistin) konzentrieren. Außerdem werden die Studenten im Laufe des Programms den innovativen One-Health-Ansatz erlernen, der sie in die Lage versetzt, das Problem der Antibiotikaresistenz aus einer ganzheitlichen Perspektive anzugehen. In diesem Sinne wird das Programm Ärzten die wirksamsten Strategien zur Verhinderung und Kontrolle der Ausbreitung von mikrobiellen Resistenzen in der Nahrungskette vermitteln.
Andererseits basiert dieser Universitätsabschluss auf der revolutionären Relearning-Methode. Dieses Lernsystem beinhaltet die Wiederholung der wichtigsten Konzepte des Studiengangs, um ein gründliches Verständnis des Inhalts zu gewährleisten. Die Zugänglichkeit ist ebenfalls ein Schlüsselfaktor, denn die Ärzte benötigen nur ein elektronisches Gerät mit Internetanschluss (z. B. ein Mobiltelefon, ein Tablet oder einen Computer), um auf den virtuellen Campus zuzugreifen und von den dynamischsten akademischen Ressourcen auf dem Markt zu profitieren. Zweifellos eine ideale Gelegenheit für Ärzte, sich ein effektives Update auf dem sehr gefragten Gebiet der multiresistenten Bakterien in der Nahrungskette zu verschaffen.
Dieses Programm gibt Ihnen die Möglichkeit, Ihr Wissen in einem realen Szenario zu aktualisieren, mit der maximalen wissenschaftlichen Präzision einer Institution, die an der Spitze
der Technologie steht"
Dieser Universitätskurs in Multiresistente Bakterien in der Nahrungskette enthält das vollständigste und aktuellste wissenschaftliche Programm auf dem Markt. Die wichtigsten Merkmale sind:
- Entwicklung von Fallstudien, die von Experten für Mikrobiologie, Medizin und Parasitologie vorgestellt werden
- Der anschauliche, schematische und äußerst praxisnahe Inhalt vermittelt alle für die berufliche Praxis unverzichtbaren wissenschaftlichen und praktischen Informationen
- Die praktischen Übungen, bei denen der Selbstbewertungsprozess zur Verbesserung des Lernens durchgeführt werden kann
- Sein besonderer Schwerpunkt liegt auf innovativen Methoden
- Theoretische Lektionen, Fragen an den Experten, Diskussionsforen zu kontroversen Themen und individuelle Reflexionsarbeit
- Die Verfügbarkeit des Zugriffs auf die Inhalte von jedem festen oder tragbaren Gerät mit Internetanschluss
Sie werden Ihr Verständnis des One-Health-Konzepts vertiefen, das es Ihnen ermöglichen wird, das Risiko der Antibiotikaresistenz deutlich zu verringern“
Das Dozententeam des Programms besteht aus Experten des Sektors, die ihre Berufserfahrung in diese Fortbildung einbringen, sowie aus renommierten Fachkräften von führenden Gesellschaften und angesehenen Universitäten.
Die multimedialen Inhalte, die mit der neuesten Bildungstechnologie entwickelt wurden, werden der Fachkraft ein situiertes und kontextbezogenes Lernen ermöglichen, d. h. eine simulierte Umgebung, die eine immersive Fortbildung bietet, die auf die Ausführung von realen Situationen ausgerichtet ist.
Das Konzept dieses Programms konzentriert sich auf problemorientiertes Lernen, bei dem die Fachkraft versuchen muss, die verschiedenen Situationen aus der beruflichen Praxis zu lösen, die während des gesamten Studiengangs gestellt werden. Zu diesem Zweck wird sie von einem innovativen interaktiven Videosystem unterstützt, das von renommierten Experten entwickelt wurde.
Möchten Sie modernste Methoden zur Bewältigung von Krisensituationen im Zusammenhang mit dem Ausbruch von multiresistenten Bakterien in Ihre tägliche Praxis integrieren? Erreichen Sie das mit diesem Programm"

Dank des Relearning-Systems, das TECH Ihnen zur Verfügung stellt, können Sie Ihr Wissen in Ihrem eigenen Tempo und ohne Zeitdruck aktualisieren"
Lehrplan
Im Rahmen dieses Universitätsprogramms werden Ärzte ein solides Verständnis der Epidemiologie von multiresistenten Bakterien in der Nahrungskette erwerben. Der Studiengang konzentriert sich auf die Rolle von Lebensmitteln bei der Ausbreitung von Antibiotikaresistenzen, wobei insbesondere der One-Health-Ansatz untersucht wird. Diese Strategie wird es den Studenten ermöglichen, die Resistenz gegen antimikrobielle Mittel in einem frühen Stadium zu erkennen, was eine rechtzeitige Behandlung ermöglichen wird. Ebenso wird das Programm den Experten die fortschrittlichsten Strategien zur wirksamen Vorbeugung und Kontrolle der Ausbreitung von mikrobiellen Resistenzen in der Nahrungskette vermitteln.
Sie werden hochqualifiziert sein, um die wirksamsten Antibiotikabehandlungen auf der Grundlage von erregerspezifischen Resistenzprofilen auszuwählen“
Modul 1. Multiresistente Bakterien in der Nahrungskette
1.1. Multiresistente Bakterien in der Nahrungskette
1.1.1. Die Rolle der Nahrungskette bei der Verbreitung der antimikrobiellen Resistenz
1.1.2. Antimikrobielle Resistenz in Lebensmitteln (ESBL, MRSA und Colistin)
1.1.3. Die Nahrungskette im Rahmen des One-Health-Konzepts
1.2. Verbreitung der Resistenz gegen antimikrobielle Mittel durch Lebensmittel
1.2.1. Lebensmittel tierischen Ursprungs
1.2.2. Lebensmittel pflanzlichen Ursprungs
1.2.3. Verbreitung von resistenten Bakterien über das Wasser
1.3. Verbreitung resistenter Bakterien in der Lebensmittelproduktion
1.3.1. Verbreitung resistenter Bakterien im Umfeld der Lebensmittelproduktion
1.3.2. Verbreitung resistenter Bakterien durch Lebensmittelarbeiter
1.3.3. Kreuzresistenz zwischen Bioziden und Antibiotika
1.4. Resistenz gegen antimikrobielle Mittel bei Salmonella spp.
1.4.1. Salmonella spp., die AmpC, ESBL und Carbapenemasen produzieren
1.4.2. Resistente Salmonella spp. beim Menschen
1.4.3. Antibiotikaresistente Salmonella spp. bei Nutz- und Fleischtieren
1.4.4. Multiresistente Salmonella spp.
1.5. Resistenz gegen antimikrobielle Mittel bei Campylobacter spp.
1.5.1. Resistenz gegen antimikrobielle Mittel bei Campylobacter spp.
1.5.2. Antibiotikaresistente Campylobacter spp. in Lebensmitteln
1.5.3. Multiresistente Campylobacter spp.
1.6. Antimikrobielle Resistenz bei Escherichia coli
1.6.1. E. coli., die AmpC, ESBL und Carbapenemasen produzieren
1.6.2. Antibiotikaresistente E. coli bei Nutztieren
1.6.3. Antibiotikaresistente E. coli in Lebensmitteln
1.6.4. Multiresistente E. coli
1.7. Antimikrobielle Resistenz bei Staphylokokken
1.7.1. Methicillin-resistenter S. aureus (MRSA)
1.7.2. MRSA in Lebensmitteln und Nutztieren
1.7.3. Methicillin-resistente Staphylococcuys epidermidis (MRSE)
1.7.4. Multiresistente Staphylococcus spp.
1.8. Antimikrobielle Resistenz bei Enterobacteriaceae
1.8.1. Shigella spp.
1.8.2. Enterobacter spp.
1.8.3. Andere Enterobakterien aus der Umwelt
1.9. Antimikrobielle Resistenz bei anderen lebensmittelbedingten Krankheitserregern
1.9.1. Listeria monocytogenes
1.9.2. Enterococcus spp.
1.9.3. Pseudomonas spp.
1.9.4. Aeromonas spp. und Plesiomonas spp.
1.10. Strategien zur Verhinderung und Kontrolle der Ausbreitung von mikrobiellen Resistenzen in der Lebensmittelkette
1.10.1. Präventiv- und Kontrollmaßnahmen in der Primärproduktion
1.10.2. Präventiv- und Kontrollmaßnahmen in Schlachthöfen
1.10.3. Präventiv- und Kontrollmaßnahmen in der Lebensmittelindustrie

Ein kontextbezogenes und realistisches Studium, das Sie in die Realität eines Berufs voller Herausforderungen eintauchen lässt. Schreiben Sie sich jetzt ein!
Universitätskurs in Multiresistente Bakterien in der Nahrungskette
Der Universitätskurs in Multiresistente Bakterien in der Nahrungskette der TECH Technologischen Universität ist eine einzigartige Gelegenheit, die Herausforderungen und Lösungen im Zusammenhang mit bakterieller Resistenz in der Lebensmittelindustrie zu erforschen. Dieses Programm richtet sich an Fachleute aus den Bereichen Gesundheit und Lebensmittelsicherheit, die ihr Wissen durch Online-Unterricht vertiefen möchten, der Flexibilität für autonomes Lernen von jedem Ort der Welt aus bietet. Als akademischer Marktführer in der Branche sind wir bestrebt, eine qualitativ hochwertige Weiterbildung anzubieten, die fortschrittliche Theorie und praktische Anwendungen kombiniert. Die Kursteilnehmer werden sich eingehend mit den verschiedenen Aspekten multiresistenter Bakterien in der Nahrungskette befassen, einschließlich ihrer Resistenzmechanismen, Nachweismethoden und Kontrollstrategien. Der Online-Unterricht ermöglicht den Studenten den Zugang zu aktuellen Bildungsinhalten und interaktiven Tools, die das Verständnis und die Anwendung der erlernten Konzepte erleichtern. Darüber hinaus haben die Teilnehmer die Möglichkeit, mit Experten der Lebensmittelmikrobiologie und des öffentlichen Gesundheitswesens zusammenzuarbeiten, was ihre Bildungserfahrung durch vielfältige und spezialisierte Perspektiven bereichert.
Studieren Sie multiresistente Bakterien mit TECH
Dieses Programm befasst sich mit kritischen Themen wie der Ausbreitung von Antibiotikaresistenzen in der Nahrungskette, den Auswirkungen auf die öffentliche Gesundheit und regulatorischen Strategien zur Risikominimierung. Die Studenten lernen auch die neuesten Forschungsergebnisse und Trends in der Lebensmittelmikrobiologie kennen und werden so darauf vorbereitet, sich den neuen Herausforderungen im Bereich der Lebensmittelsicherheit zu stellen. Nach Abschluss des Kurses verfügen die Absolventen über die notwendigen Fähigkeiten, um Initiativen zur Lebensmittelsicherheit und Qualitätskontrolle zu leiten, zu verbesserten Industriepraktiken beizutragen und den verantwortungsvollen Einsatz von Antibiotika in der Lebensmittelproduktion zu fördern. Schließen Sie sich der TECH Technologischen Universität an und erweitern Sie Ihr Wissen über multiresistente Bakterien in der Nahrungskette. Bereiten Sie sich darauf vor, eine führende Rolle in der Welt der Mikrobiologie einzunehmen und zur Entwicklung effektiver Lösungen für die Herausforderungen der öffentlichen Gesundheit im Zusammenhang mit bakteriellen Resistenzen beizutragen.







